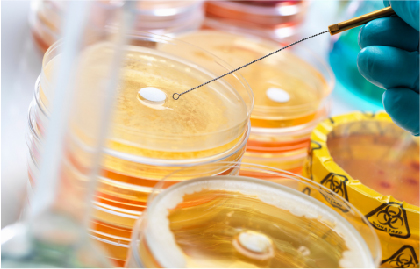
2

“禁抗”时代来临,滥用抗生素正在“降温”
来源: 发布时间:2020-05-20
4月25日,据《瞭望》新闻周刊报道,调研发现长江流域抗生素浓度偏高,水生态系统受到破坏。这不禁让人想起央视新闻报道的,复旦大学公共卫生学院近年来对上千名8~11岁儿童和516名孕妇的调查结果显示,儿童尿样中共有21种人用、兽用或人兽用抗生素检出,79.6%的学龄儿童尿液中检出一种或几种抗生素,其中部分已在临床上禁用。此外,有16种抗生素在江浙沪的孕妇尿液中检出,一种及以上抗生素检出率为41.6%,孕妇暴露较为普遍,风险较大。
>>>什么是兽用抗生素<<<
兽用抗生素是用于牲畜以治疗或预防其疾病的发生,或通过加快动物生长而提高经济效益的一类药物的统称。

按照兽用抗生素的化学结构,兽用抗生素可以分为以下几类:
1、多肽类,不易产生抗药性,不易与人用抗生素发生交叉耐药性。主要有杆菌肽锌、黏杆菌素、维吉尼亚霉素、硫肽霉素、持久霉素、恩拉霉素和阿伏霉素等,中国兽药典2010版收载杆菌肽锌、硫黏菌素原料及其制剂。
2、四环素类为广谱抗生素,连续低浓度投药有好的促生长效果,但四环素类抗生素属人畜共用抗生素,易产生抗药性。中国兽药典2010版收载盐酸四环素、盐酸多西环素(强力霉素)、盐酸金霉素、盐酸土霉素、土霉素等原料及其制剂。
3、大环内酯类,此类抗生素类是利用放线菌或小单孢菌产生的具有大环内酯环的抗生素的总称,因含有氨基糖而呈碱性。该类抗生素对革兰氏阳性菌、一些革兰氏阴性菌、耐青霉素菌的葡萄球菌、支原体都有抑制作用。主要包括泰乐菌素、北里霉素、红霉素、螺旋霉素。中国兽药典2010版收载吉他霉素、酒石酸吉他霉素、红霉素、乳糖酸红霉素、硫氰酸红霉素、泰乐菌素、酒石酸泰乐菌素、磷酸泰乐菌素、替米考星等品种及其制剂。
4、含磷多糖类,此类抗生素对革兰氏阳性菌的耐药菌株特别有效,其分子量大,不易被消化吸收、排泄快等特点,导致其在欧美被广泛使用,其中黄霉素和大碳霉素较为常见。
5、聚醚类抗生类,聚醚类抗生素抗菌谱广,具有离子运输的作用,既是很好的促生长剂,又是有效的抗球虫剂。在动物消化道内几乎不被吸收,无残留,常用的有莫能菌素、盐霉素、拉沙里霉素和马杜霉素。
6、β-内酰胺类抗生素,中国兽药典2010版收载苄星青霉素、阿莫西林、青霉素钠、青霉素钾、苯唑西林钠、氨苄西林、氯唑西林钠、普鲁卡因青霉素、头孢噻呋钠、头孢噻呋等原料及其制剂。
8、化学合成类,此类抗生素由于副作用大,正逐渐被淘汰,大部分只允许做兽药,而不用做饲料添加剂。此类抗生素有磺胺类,酰胺醇类等。
>>>兽用抗生素的出现<<<
1910年
德国医生埃尔利希发明阿斯凡纳明,可杀灭侵入人体内的梅毒细菌。
1928年
英国微生物学家亚历山大·弗莱明首次从青霉菌中发现了具有抗金黄色葡萄球菌活性的青霉素,从此进入了抗生素的黄金时代。第二次世界大战中,青霉素作为一线药用抗生素拯救了成千上万人的性命,一时名声大噪。
1939年到1943年
赛尔曼·瓦克斯曼从土壤中共分离出1万株放线菌,发现其中有10株能够产生对病原细菌有抑制作用的抗生素。1943年,他从链霉菌中分离得到了链霉素并首次系统性地定义了“抗生素”这个概念。金霉素(1947)、氯霉素(1948)、土霉素(1950)、制霉菌素(1950)、红霉素(1952)、卡那霉素(1958)等都是在这期间发现的。
1950年
美国食品与药品管理局(FDA)首次批准抗生素用作饲料添加剂。
1956年
万古霉素出现。
1961年至80年代
开始了半合成青霉素、头孢、半合成四环素和半合成红霉素时代。
1962年至90年代
喹诺酮类。

抗生素在人类卫生事业中的不断发展,也正在给畜牧业带来一场革命。抗生素在畜牧业应用的历史最早可追溯到20世纪的美国和欧洲。Moore等学者在1946年首次报告,在鸡饲料中添加少量链霉素能促进雏鸡的生长发育。此后Jukes又在1950年首次发表了猪饲料中添加抗生素的试验报告。其后开始有大量试验研究证明抗生素有促进动物生长的作用。
此外,抗生素的应用还提高种畜繁殖性能,降低死亡率的作用。Cnohiwell在1991年总结的实验结果证明,使用抗生素提高母猪受胎率7%,增加了窝产。
我国1994年农业部首次发布了饲料药物添加剂允许使用品种目录,(农牧发[1994])开始将抗生素添加剂列为饲料添加剂。经过几十年的发展,中国已经成为了抗生素使用大国。但随着人们对抗生素副作用认识的逐步深入,中国又开始限制和禁止部分抗生素的使用,也开始对滥用抗生素加强监管。
>>>抗生素污染的危害<<<
1、 病菌产生耐药性,出现“超级细菌”。
细菌耐药性是随着抗生素的使用而出现的,一种新药投入使用一般2年就会出现相应的耐药菌株,但抗生素的滥用会加速这一过程的出现,并且使一种细菌能够抵抗多种抗生素,就出现了“超级细菌”。养殖业滥用抗生素不仅会通过食物链作用到人体,孕妇在吃有大量抗生素残留的肉蛋奶以及水产品后,也很可能导致这些抗生素的摄入而造成新生儿的耐药性。

2、 引起动物免疫机能下降,死亡数增多。
养殖户过度依赖抗生素药物,未能形成良好的健康养殖意识,长期大量使用抗生素药物,破坏了动物肠道微生物系统,造成动物机体免疫力、抵抗力下降,抗毒力和抗外界感染的能力降低,从而导致疾病继发频发。

3、 破坏人体免疫力
兽用抗生素暴露会导致儿童肥胖、性早熟相关。抗生素通过饮水或食用水产品等途径进入人体和动物体内后无法完全代谢,长时间摄入后,抗生素跟随血液循环遍布多个器官,造成免疫力逐渐降低。此外还会引发人体的耐药性,最后培养出超级耐药菌肆虐,可能导致无药可用的境地。
>>>抗生素在我国的“疯狂”<<<
我国是世界上最大的抗生素生产和使用国,自然也就是抗生素滥用和细菌耐药性的重灾区,畜牧业领域尤其严重。出现了几次食品安全的标志性事件。
2001年,奥地利、德国以及其他西欧部分国家相继在中国出口的大虾含有氯霉素成份。最终导致了欧盟讨论通过决议,全面禁止从中国进口所有动物源性产品。氯霉素事件由此引发了!
据不完全统计,2001年我国向欧盟出口的水产企业总数为95家,2002年每个企业因欧盟禁令所遭受的损失平均在300-500万美元之间,95家企业对欧盟水产品出口贸易金额合计6.23亿美元。此后,美国、日本等国家也对中国出口水产品进行了警示。
在未实行处方制,一名区县兽药经营者接受媒体采访时表示,兽用抗生素基本上“想买多少就买多少”,仅一种叫枝原净的抗生素,一年就能卖出100多公斤。

>>>“禁抗”之路的开始<<<
抗生素“野蛮生长”开始逐渐变成社会与政府的痛点,也催生了一系列针对性的标准和法律的产生,同时也让普通人对兽用抗生素的危害有了初步的了解。事实上除中国以外,世界各国的“禁抗”之路已经早早的开始了。
1986年瑞典率先禁止了促生长抗生素的使用;10年后,到2006年欧盟全面禁止促生长抗生素的使用;2年后,2008年美国的泰森、史密斯菲尔德、嘉吉等多家国际肉类加工巨头在美国主动停止在饲料中添加促生长抗生素,2014年美国宣布未来三年逐步禁止促生长抗生素。
2016年我国才开始“禁抗”之路。2017年禁止硫酸粘杆菌素添加在饲料中。2019年,农业农村部的第194号文规定,要求从2020年起在饲料中全面禁止使用除中药外的所有促生长类药物饲料添加剂。这意味着全国动物养殖业将全面迎来“禁抗”、“减抗”、“替抗”新发展时期。
>>>“禁抗”的方法论<<<
“禁抗”最直接的指向就是抗生素残留的问题,无论是从技术、管理层面还是在检测技术层面,都对解决抗生素残留问题有重要意义。国家层面的管理对抗生素残留的具有大局意义,而检测技术则是企业遵守法律标准以及规避风险的重要方法。
畜禽产品抗生素残留的主要检测方法

一般说来,各种畜、禽、鱼的肌肉、脂肪、肝、肾、奶、蛋都可成为抗生素残留污染的部位。抗生素残留的常规检测方法根据检测原理的不同主要包括生物检测法、理化检测法。
1、 生物检测法主要包括微生物检测法、免疫分析法、生物传感器方法
抗生素微生物检测法是一种经典的方法,可直观、特异地反应出抗生素药品的抗菌活性。其原理是根据抗生素对微生物的代谢和机能具有抑制作用,利用该性质可实现对样品中的抗生素残留进行定性或定量分析。微生物法检测抗生素残留的代表方法主要包括稀释法、浊度法、琼脂扩散法、微生物受体检测法。微生物检测法费用低,但是花费时间长、灵敏度低,只适用于实验室少量样品检测及样品的初筛查,当出现阳性样品时,还需要使用其他方法进一步确定。
免疫分析法是利用抗原和抗体的特异性结合等特征,进行抗生素残留检测的一种方法。代表方法主要有化学发光免疫分析、酶联免疫分析、荧光免疫分析、放射免疫分析、免疫传感器等。其中酶联免疫分析法是免疫分析法中使用最为广泛的方法,随着近些年来酶制备、抗体制备等技术的发展,该技术发展迅速并得到了很多国家的认可,但检测成本较其他方法高。
2、理化检测方法主要包括毛细管电泳法、高效液相色谱法、液-质联用法、超临界流体色谱法。
随着科技的发展,分离分析技术的提高,抗生素的分子结构及成分更加清楚,所以很多抗生素检测都改为高效液相色谱法、串联质谱法及其他仪器测定法检测,既准确又快速。

高效液相色谱法(HPLC)由于具有分离效能好、灵敏度高和分离速度快等特点,是目前国内抗生素残留检测最普遍最有效的方法,所用的检测器主要有紫外检测器、荧光检测器、以及二级管阵列检测器。例如:多数大环内酯类抗生素在紫外下都有较强的吸收,因此常用紫外检测器(UV)检测肌肉、猪肝、鸡肉和牛肉中的土霉素、四环素、金霉素、强力霉素。
色谱质谱的联用技术将液相色谱仪有效分离的能力和质谱的定性功能结合起来,相当于给液相色谱配备了一台质谱仪作为检测器,因此产生了液-质联用法(LC-MS)。利用色谱和质谱的联用技术可以提高抗生素的定性、定量分析的可靠性、准确性、灵敏度,对复杂化合物中微量和痕量组分的定性和定量分析具有重要的意义。

而在国家层面的管理方面,农业部也开始将影响动物源性食品安全的兽用抗生素的管理当作重点治理对象,淘汰安全隐患品种,已禁止洛美沙星、培氟沙星、氧氟沙星、诺氟沙星等4种人兽共用抗生素用于食品动物,禁止硫酸黏菌素预混剂用于动物促生长;监测猪肉、鸡肉等主要畜禽产品9类70种兽药残留;监测生猪、家禽、奶牛等动物饲养场5种主要细菌对16种兽用抗生素的耐药状况,建立耐药性数据库;开始主动推动形成政府主导、企业参与、社会共治的健康局面。